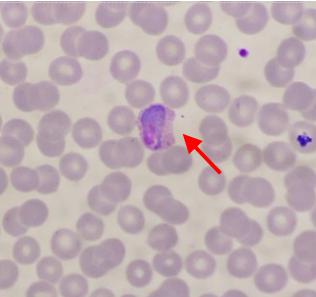

22岁小伙突然发烧头痛咳嗽,竟是因为一年多前出国游玩
22岁小伙突然发烧头痛咳嗽,竟是因为一年多前出国游玩
年轻小伙忽冷忽热,血小板骤低
6 月初,深夜 11 点多,一位 22 岁的患者小吕(化名)匆匆忙忙奔来瑞金医院嘉定院区急诊。他已经连续发烧 2 天了,体温最高为 37.7 ℃,伴随着头痛和咳嗽,不规则发冷发热症状。
正在值班的陆桢兵医生仔细询问了病史,得知他既往体健,没有基础疾病。经过检查发现患者咽红肿,两肺呼吸音粗,没有明显的胸闷气短和腹泻等症状。陆医生初步诊断为呼吸道感染,开具了血常规检测。然而,检验科夜班技师杨迟晖在审核血常规结果时,却发现了一个不寻常的现象:患者的血小板偏低,仅为 87 x10 ⁹ /L(参考范围:125-350 x10 ⁹ /L),其他指标基本正常。" 患者既年轻,又没有基础病,为什么会出现血小板降低的情况呢?" 杨迟晖感到很疑惑。

仔细查看血常规分析仪的详细参数后,发现该标本散点图异常,提示有感染红细胞。这一发现引起了杨迟晖的高度重视,她立即进行了血涂片的人工镜检。在显微镜下,惊讶地发现大量疟原虫滋养体。这一发现让她突然警觉起来,难道这名患者感染的是疟原虫,而非普通的呼吸道感染?

" 我最近一年都在上海,家人也没出境。" 面对陆医生的询问,小吕回忆自己和家人一直在家里," 一年多以前出国玩了一趟。" 面对眼前的检查结果和患者症状,医生不得不谨慎起来。上海市已于 2010 年消除本地感染疟疾,2016 年率先通过国家消除疟疾评估,实现了消除疟疾目标。至 2023 年,已经连续 14 年无本地感染疟疾发生,连续 7 年维持消除疟疾状态。
陆医生赶忙与感染科值班医生赵钢德会诊,再次确认后联系嘉定区疾控中心,将患者血样送检。疾控中心通过 RDT 快速检测、镜检及核酸检测后,最终诊断为:间日疟原虫感染。
潜伏期长达一年,重症发作可致命
" 疟疾主要是通过蚊虫叮咬传播的,一般潜伏期短则数周,但长则可达一年左右。" 陆桢兵医生解释道," 患者属于异常的潜伏期,可能一年前在境外无意间感染了,直到一年后才出现症状。" 所幸,由于发现及时,小吕得到了迅速治疗,从而控制了疾病的进展。" 还好来了瑞金医院,真想不到是这个原因 ......" 小吕庆幸道。
疟疾是一种由疟原虫引起的严重危害人类健康的传染性疾病,其主要传播途径是通过蚊虫叮咬。蚊虫在叮咬带有疟原虫的患者后,会将疟原虫吸入体内,并在叮咬下一个健康人时将其传播出去。疟原虫寄生于人体后,会移行至肝脏进行繁殖,而后离开肝脏,侵入红细胞内,并再次繁殖,导致红细胞破裂,引发一系列临床症状,包括发冷、发热、大汗、头痛、四肢酸痛和乏力等。最初的症状可能比较轻微,类似于许多发热性疾病,并且难以识别为疟疾。这些症状在感染后的一定潜伏期内反复出现,对患者造成极大的痛苦。在严重的情况下,疟疾还可能引发贫血、低血糖、急性肾功能衰竭或急性肺水肿等并发症,甚至危及生命。
对于疟疾的治疗,关键在于及时发现和全程足量服用抗疟疾药。抗疟药物包括氯喹、奎宁、青蒿素等,其选择取决于患者的年龄、病情严重程度、疟原虫的耐药性等因素。大多数疟疾患者经过及时治疗可以治愈。然而,如果延误治疗或治疗不当,可能会导致病情加重甚至危及生命。
防蚊是关键,前往这些区域要警惕
疟疾分为多种类型,包括间日疟、卵形疟、三日疟和恶性疟等,其中恶性疟病情最为严重。潜伏期因疟原虫种类和宿主免疫状态而不同,间日疟短者一般为 12-30 天,长者可达 1 年左右;卵形疟与间日疟相仿;三日疟为 18-40 天;恶性疟为 11-16 天。不同类型的疟疾发作频率也有差异:间日疟和卵形疟每 48 小时发作一次,三日疟每 72 小时发作一次,恶性疟每 24-48 小时发作一次。
哪些地方是疟疾高发地区?
根据世界卫生组织(WHO)的数据, 2022 年全球有 2.49 亿人感染疟疾,并导致 60.8 万人死亡。主要流行地区分布在非洲、东南亚等地。非洲疟疾病例数占全球 94%,疟疾死亡数占全球疟疾的 95%;东南亚的印度、印度尼西亚和缅甸三个国家的病例数占东南亚区域疟疾病例的 99%。2021 年我国正式获得世界卫生组织疟疾消除认证。但上海作为特大型口岸城市,对外交流频繁,人员流动性强,输入性疟疾引起本土再传播的风险持续存在。
医生提醒
去过疟疾高发地区后,一旦出现交替发冷发热、出汗、乏力等症状时,要尽快就医并主动告知旅行史和接触史等信息,以便及时诊断和治疗。
预防疟疾的关键在于防蚊灭蚊。现在正值夏季,是蚊虫活动的高峰期,我们要注意避免蚊虫叮咬,做好防护措施。在户外活动时,暴露的皮肤可涂抹驱蚊剂;在家中可使用蚊帐、纱窗等防蚊设施;保持周围环境清洁,清除垃圾、杂草、积水,根除蚊虫孳生场所;外出旅行时,尤其是前往疟疾高发地区时,要特别注意防蚊措施。
-
- 恶意USB手机充电线,正在悄悄窃取公司和个人隐私
-
2024-07-05 16:19:50
-
- 一组罕见老照片,妓女街头强拉男客,日本慰安妇慰劳美国大兵
-
2024-07-04 19:28:34
-
- 盘点三部唯美的古风漫画,完美的画风,动人的爱情
-
2024-07-04 19:26:18
-
- 行云流水的元丰通宝铜钱
-
2024-07-04 19:24:02
-
- 一组泳池 写真
-
2024-07-04 19:21:46
-
- 漂亮美女小姐姐的生活照,每一张都让人倾心。
-
2024-07-04 19:19:30
-
- 印度首次出现女多男少引热议
-
2024-07-04 19:17:14
-
- 行走边境小城阿拉山口
-
2024-07-04 19:14:58
-
- 拥有完美身材的5大女星:baby垫底,热巴第二,第一是大长腿的她
-
2024-07-04 19:12:42
-
- 硬件干货---关于菲律宾驾照指南
-
2024-07-04 19:10:26
-
- 帮你写脚本、剪片、找素材,AI 视频编辑应用 Google Vids 上线测试
-
2024-07-04 19:08:11
-
- 3万余瓶飞天茅台被抢获利2000余万元!来看警方最新披露
-
2024-07-01 16:48:15
-
- 拜登承认首轮辩论表现不佳 特朗普、奥巴马发声
-
2024-07-01 16:46:00
-
- 解除免费乘车儿童数量限制,广州发布新版城市轨道交通乘客守则
-
2024-07-01 16:43:44
-
- 单亲妈妈从7楼狂扔物品获刑:因女儿夜不归宿爆发争吵
-
2024-07-01 16:41:28
-
- 夏日开胃小菜,蛇皮黄瓜,美味又简单!
-
2024-07-01 16:39:12
-
- 盒马开启扩张新纪元
-
2024-07-01 16:36:56
-
- 夏日炎炎 博物馆成“避暑胜地”
-
2024-07-01 16:34:40
-
- 银行回应男子取亡父存款被要求证明“我爸是我爸”,律师:属必然要求,但建议
-
2024-07-01 16:32:24
-
- 仙剑奇侠传中的爱情,被人忽略的真相!
-
2024-07-01 16:30:08



难得的好小品演员,黄杨 在饭米粒儿中饰演黄小黄
唐朝刺史是几品?唐朝刺史相当于现在什么官
略备薄酒还是略备薄宴 略备薄酒以小酌的意思
张云雷为什么是回族 张云雷的回族名字叫什么
玉化砗磲手串一般多少钱?这份价格清单请收好
曾梦想仗剑走天涯是什么歌谁唱的 曾经的你完整歌词介绍
otc是什么意思(OTC是什么意思?深入解析OTC市场)
机械制图基础知识:圆弧、圆弧连接及其正确画法
王梦秋九龙珠事件 鹿晗七龙珠事件实锤曝光全是黑粉ps
远房的亲戚是什么意思 远房亲戚怎么定义